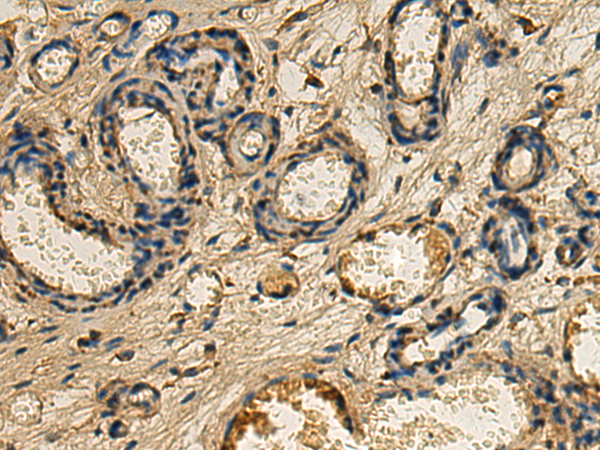

-
分类: 科研抗体货号: P01670别名: GSL; GLB2; NGBE; PPCA; PPGB应用: WB反应种属: Human, Mouse
-
分类: 科研抗体货号: P01628别名: Nup75应用: WB反应种属: Human, Mouse, Rat
-
分类: 科研抗体货号: P01703别名: NGAP应用: WB反应种属: Human, Mouse
-
分类: 科研抗体货号: P01666别名: Lobe; PRAS40应用: IHC反应种属: Human, Mouse
-
分类: 科研抗体货号: P01621别名: PAI; PAI2; PAI-2; PLANH2; HsT1201应用: IHC反应种属: Human, Mouse
-
分类: 科研抗体货号: P01702别名: RASAL应用: IHC反应种属: Human, Mouse
-
分类: 科研抗体货号: P01664别名: G4-1; G5pr; C14orf10应用: IHC反应种属: Human, Mouse, Rat
-
分类: 科研抗体货号: P01615别名: OTB2; OTU2; C14orf137应用: WB反应种属: Human, Mouse
-
分类: 科研抗体货号: P01660别名: PP2CA; PP2Calpha; PP2C-ALPHA应用: WB,IHC反应种属: Human, Mouse, Rat
-
分类: 科研抗体货号: P01698别名: Gle2; MIG14; MRNP41; Mnrp41; dJ481F12.3; dJ800J21.1应用: WB,IHC反应种属: Human, Mouse, Rat

鄂公网安备42018502007531号
鄂公网安备42018502007531号

